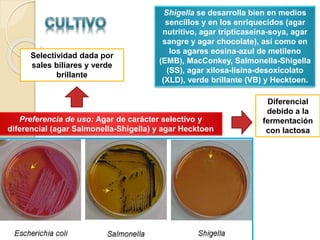
Shigella se desarrolla bien en medios
sencillos y en los enriquecidos (agar
nutritivo, agar tripticaseína-soya, agar
sangre y agar chocolate), así como en
los agares eosina-azul de metileno
(EMB), MacConkey, Salmonella-Shigella
(SS), agar xilosa-lisina-desoxicolato
(XLD), verde brillante (VB) y Hecktoen.
Preferencia de uso: Agar de carácter selectivo y
diferencial (agar Salmonella-Shigella) y agar Hecktoen
Selectividad dada por
sales biliares y verde
brillante
Diferencial
debido a la
fermentación
con lactosa

El documento describe Shigella dysenteriae, la bacteria causante de la disentería. Explica que utiliza un sistema de secreción tipo III (SSTT) para infiltrar las células intestinales y liberar proteínas efectores que desestabilizan el citoesqueleto y permiten la invasión. También produce toxinas como la toxina Shiga que causan daño al epitelio intestinal y síntomas como diarrea sanguinolienta. El tratamiento incluye antibióticos y medidas de prevención como el lavado de manos y la cocción adecuada de








![[10-500] bacterias viables
(Shigella dysenteriae)
Agua o alimentos contaminados
Resistencia a la acidez
Mecanismo 2Mecanismo 1
Glucosa
GDAR
Mucosa gástrica
Vía oral
Epitelio del colon
Células M
Fagocitosis por
Macrófago
ipaC
Shigella dysenteriae
SSTT ipaB
Caspasa-1
Apoptosis de
Macrófago
Entrada a
Enterocito
- IL-1-β
- IL-18
Neutrófilo
Transmigración
(desestabiliza
barrera epitelial)](https://image.slidesharecdn.com/shigelladysenteriae-150613224842-lva1-app6891/85/Shigella-dysenteriae-9-320.jpg)







![ [1-2] días:
◦ Fiebre transitoria.
◦ Diarrea acuosa.
◦ Diarrea sanguinolienta y disentería.
DISENTERÍA:
◦ Expulsión frecuente ([10-30] /día) de heces escasas que
contienen sangre, moco y pus.
◦ Cólicos abdominales intensos y tenesmo.
◦ Pujo con dolor.
DISENTERÍA GRAVE:
◦ Suele entrañar infección por S. dysenteriae de tipo 1, y con
menor frecuencia por S. Flexneri; ocupa el 3er lugar S. sonnei o
S. boydii.
◦ Evoluciona hasta la dilatación tóxica y la perforación del colon, y
uno y otro cuadros pueden ser mortales.](https://image.slidesharecdn.com/shigelladysenteriae-150613224842-lva1-app6891/85/Shigella-dysenteriae-17-320.jpg)

![ Ahmed F et al: Epidemiology of postshigellosis persistent diarrhea in young children. Pediatr Infect
Dis J 20:525, 2001 [PMID: 11368112] Baer JT et al: HIV infection as a risk factor for shigellosis.
Emerg Infect Dis 5:820, 1999 [PMID: 10603219]
Kotloff KL, Winickoff JP, Ivanoff B, Clemens JD, Swerdlow DL, Sansonetti PJ, Adak GK, and
Levine MM. Global burden of Shigella infections: implication for vaccine development and
implementation. Bull World Health Organ 77: 651–666, 2010.
Faruque AS et al: Shigellosis in children: A clinico-epidemiological comparison between Shigella
dysenteriae type 1 and Shigella flexneri. Ann Trop Paediatr 18:197, 1998 [PMID: 9924557].
Gendrel D et al: Fluoroquinolones in paediatrics. Paediatr Drugs 3:365, 2001 [PMID: 11393329]
Gibson LL et al: Quantitative assessment of risk reduction from hand washing with antibacterial
soaps. J Appl Microbiol 92:136S, 2002
Khan WA et al: Central nervous system manifestations of childhood shigellosis: Prevalence, risk
factors, and outcome. Pediatrics 103:E18, 1999
Kotloff KL et al: Global burden of Shigella infection: Implications for vaccine development and
implementation of control strategies. Bull World Health Organ 77:651, 1999 [PMID: 10516787]
Reis R. Enteropathogenic Escherichia coli, Samonella, Shigella and Yersinia: cellular aspects of host-
bacteria interactions in enteric diseases. Gut Pathogens 2010, 2:8 Obtenido de:
http://www.gutpathogens.com/content/2/1/8
Molina J. Infecciones por Shigella sp , 2011. Obtenido de:
http://www.facmed.unam.mx/deptos/microbiologia/bacteriologia/shigella.html
Jawetz, Melnic y Adelberg, «Microbiología médica», pág.. 165 – 167.
Murray P. Microbiología médica 5° edición. Editorial Elsevier; 2006 (s.a) Shigella. Obtenido de:
http://www.bvsops.org.uy/pdf/shigella.pdf
Shigellosis: from symptoms to molecular pathogenesis pdf - Philippe J. Sansonetti Am J
Physiol Gastrointest Liver Physiol 280:G319-G323, 2009.](https://image.slidesharecdn.com/shigelladysenteriae-150613224842-lva1-app6891/85/Shigella-dysenteriae-23-320.jpg)